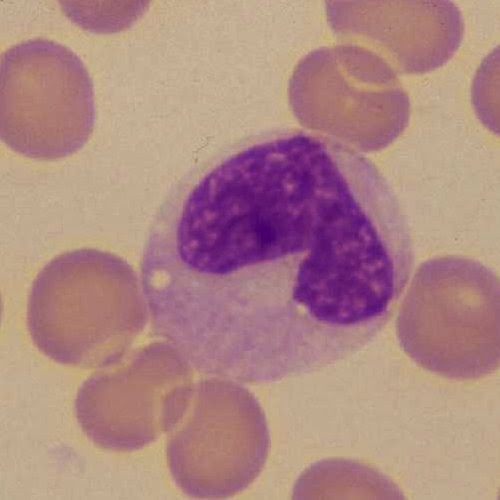

Los monocitos son un tipo de glóbulos blancos que luchan contra determinadas infecciones y ayudan a otros leucocitos a eliminar tejidos muertos o dañados, destruir células cancerosas y regular la inmunidad contra sustancias extrañas.. Se producen en la médula ósea y luego entran en la sangre, donde representan entre el 1 y el 10% de los glóbulos blancos circulantes (de 200 a 600.. Los valores de monocitos elevados también pueden ser consecuencia de enfermedades tipo cáncer como: Leucemia. Linfoma Hodgkin. Mieloma múltiple. Síndrome mielodisplásico. En estos últimos casos, los niveles altos de monocitos se deben a la presencia de células anormales que producen daños y que deben ser eliminadas.

HIstologia mayo 2018

🩸Que significa tener NEUTROFILOS, EOSINOFILOS Y MONOCITOS Altos🔬 shorts YouTube

¿Qué son los monocitos? Revista PEM

Monocitos altos en sangre síntomas y tratamientos YouTube
Fichero de Hematología Monocito

Neutrofilos Bajos Y Eosinofilos Altos

Monócitos Altos ou Baixos no Exame de Sangue O Que Isso Significa?

Qué significa tener los monocitos altos

Álbumes 105+ Foto Que Es Monocitos En La Sangre Lleno

Monocitos altos causas, síntomas y significado en el embarazo Infografías y Remedios

¿Qué significa tener el hemograma con monocitos altos y cómo afecta nuestra salud? LaVidactual

Monocitos Altos en Sangre ⇒ 【↓Síntomas y Tratamiento↓】

Monocitos características, funciones, valores, enfermedades

Monocito

Monocitos altos Qué significa, causas, valores, cómo bajarlos y más.

Leucocitosis qué indican los leucocitos altos YouTube

(PDF) Monocitos Altos ¿Cómo bajarlos? Causas, Síntomas y Tratamiento

¿Qué significa tener los Monocitos altos?

Monocitos altos Qué significa, causas, valores, cómo bajarlos y más.

¿Qué significa tener los Monocitos altos?
El término médico empleado por tener un alto conteo de monocitos es "monocitosis". Tener monocitos altos significa que hay un número elevado de estas células en la sangre. Cuando los niveles de monocitos están elevados, puede ser un indicador de que el organismo está enfrentando una infección, enfermedad, trastorno hematológico u otra.. Cuando tu nivel de monocitos es alto, lo que se conoce como monocitosis, significa que tu cuerpo está luchando contra algo. Algunas afecciones que pueden causar un aumento en los monocitos en la.